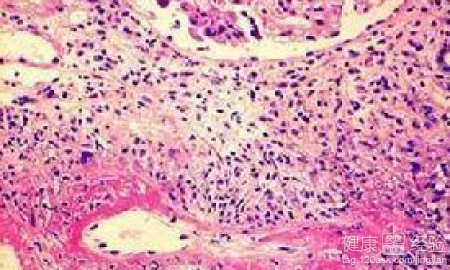
網狀青斑和血管疾病有關系嗎

最近朋友因為外出旅游的原因,回來之後自己的身上不知道是怎麼回事的就無緣無故的起來了很多的青斑,他的症狀看上去讓人有點害怕,因為朋友怕自己是感染上了一些什麼怪病,又怕是什麼血管類的疾病,最後朋友還是到醫院做了檢查,檢查的結果是網狀青斑,但是醫生沒有解釋清楚這樣的疾病有什麼症狀還有和血管疾病有沒有關系,最後我朋友就想知道網狀青斑和血管疾病有關系嗎?
1網狀青斑這類疾病是由於一種皮膚局部血管舒縮功能紊亂,導致了自身的細小動脈痙攣和細小靜脈產生擴張,自身的血液產生了堵塞從而出現了皮膚局限性的紫藍色網狀青斑。也就是說這是一類血管局部產生的疾病。
2對於血管疾病來說是有很多的誤區的,但是血管疾病一般主要指動脈像粥一樣產生硬化現象,血管產生炎症性血管疾病,血管的功能無法正常發揮的血管疾病,還有就是我們都不太熟悉的血管的真性腫瘤性疾病等。

3網狀青斑和血管疾病是有一定的關系的,因為網狀青斑已經說過是因為皮膚局部血管功能紊亂,也就是說是因為自身的皮膚血管有問題了所以導致了皮膚看上去有青斑,也可以說網狀青斑也屬於一種血管類的疾病。
作為一個網狀青斑的患者來說,最好的就是讓自身的生活習慣保持到良好的狀態,因為這類疾病會因為不同是原因而產生反應,所以最好的就是做到讓自己遠離誘病根源。